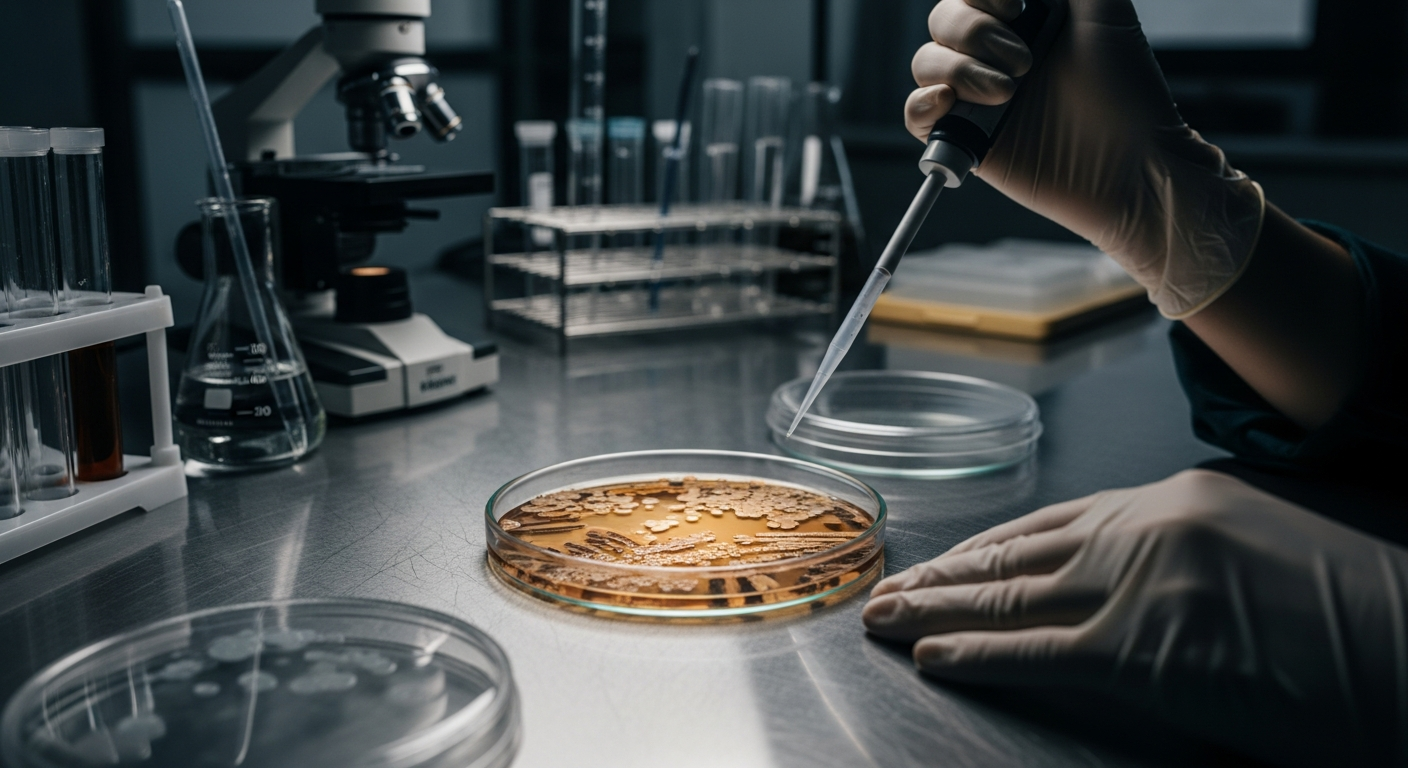
Factores que afectan el sistema gastrointestinal

En la era digital actual, la educación ha trascendido los límites físicos, abriendo nuevas...
El sistema gastrointestinal es una red compleja que va más allá de la simple descomposición de...
El acceso a un vehículo propio ha evolucionado significativamente en los últimos años, pasando de...
La elección de un sistema de delimitación adecuado es fundamental para cualquier propietario que...